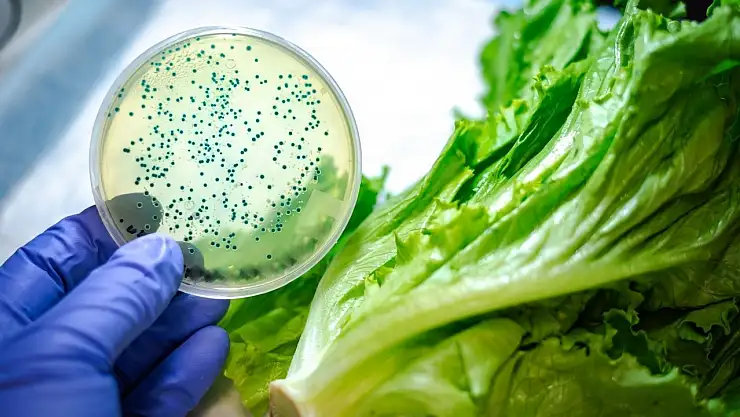
Çapraz Bulaşma Nedir?

Çapraz Bulaşma Nedir?
Çapraz bulaşma nedir örnek? Çapraz bulaşma nasıl önlenir? Çapraz bulaşma nedir ilaç? Çapraz bulaşmaya neden olan besin dışı etmenler nelerdir?
Çapraz bulaşma, mikroorganizmaların veya zararlı maddelerin bir gıdadan, yüzeyden ya da ekipmandan başka bir gıdaya veya ortama taşınmasıdır. Bu durum gıda zehirlenmelerine ve sağlık sorunlarına yol açabilir.
Çapraz Bulaşma Nedir?
- Tanım: Çapraz bulaşma (çapraz kontaminasyon), mikroorganizmaların veya kimyasal/fiziksel kirleticilerin bir kaynaktan başka bir ürüne veya yüzeye geçmesidir.
- Örnek: Çiğ tavuk kesildikten sonra aynı bıçakla salata doğramak; tavuktaki Salmonella bakterilerinin salataya bulaşması.
Çapraz Bulaşma Türleri
- Biyolojik bulaşma: Bakteri, virüs, mantar gibi mikroorganizmaların taşınması.
- Kimyasal bulaşma: Temizlik maddeleri, ilaç kalıntıları veya pestisitlerin gıdaya geçmesi.
- Fiziksel bulaşma: Saç, metal parçaları, plastik gibi yabancı maddelerin gıdaya karışması.
Çapraz Bulaşma Nasıl Önlenir?
- Çiğ ve pişmiş gıdaları ayrı tutmak.
- Ayrı kesme tahtaları ve bıçaklar kullanmak.
- Eller ve yüzeyleri sık sık yıkamak.
- Gıdaları uygun sıcaklıkta saklamak.
- Endüstriyel mutfaklarda hijyen standartlarına uymak.
Çapraz Bulaşma ve İlaç
- İlaç bağlamında çapraz bulaşma, ilaç üretiminde farklı ürünlerin birbirine bulaşması anlamına gelir.
- Örneğin, bir üretim hattında antibiyotik kalıntılarının başka bir ilaca geçmesi ciddi sağlık riskleri doğurur.
- Bu nedenle ilaç endüstrisinde katı temizlik ve üretim protokolleri uygulanır.
Besin Dışı Etmenler
Çapraz bulaşmaya yalnızca gıdalar değil, besin dışı faktörler de neden olabilir:
- Eller: Hijyenik olmayan eller mikroorganizmaları taşır.
- Ekipman ve yüzeyler: Bıçak, kesme tahtası, mutfak tezgâhı.
- Su ve hava: Kirli su veya havadaki partiküller gıdaya bulaşabilir.
- Ambalaj ve depolama koşulları: Uygun olmayan paketleme veya kirli kutular bulaşmaya yol açar.
Çapraz bulaşma, hem gıda güvenliği hem de ilaç üretiminde kritik bir risk faktörüdür. En önemli korunma yöntemi hijyen ve ayrıştırmadır. Çiğ ve pişmiş gıdaların ayrılması, ekipman temizliği ve üretim standartlarına uyulmasıyla bu risk büyük ölçüde azaltılabilir.
Bakmadan Geçme